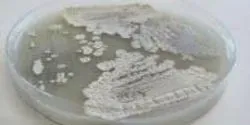

green energy

Analysis of bacteria shows efficient ways we might mimic their abilities to tear up cellulose to make fuel from otherwise unusable plant material
| 4 min read
Analysis of bacteria shows efficient ways we might mimic their abilities to tear up cellulose to make fuel from otherwise unusable plant material